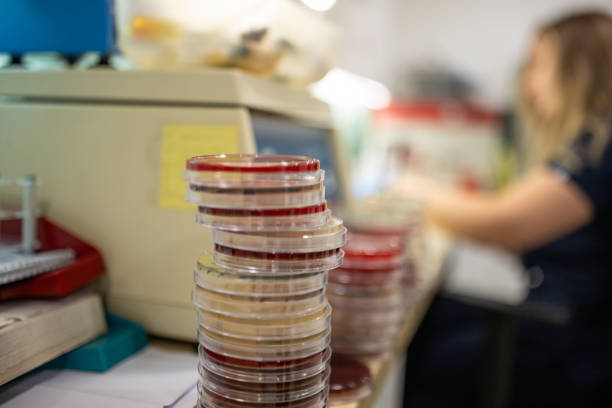
توسعه وب و طراحی پرتال نوبتدهی آنلاین برای آزمایشگاههای تخصصی پاتوبیولوژی در مشهد: ارتقاء UX بیماران و وبسایت سلامت 2026 - آزمایشگاه پاتوبیولوژی و نوبتدهی آنلاین

توسعه وب و طراحی پرتال نوبتدهی آنلاین برای آزمایشگاههای تخصصی پاتوبیولوژی در مشهد: ارتقاء UX بیماران و وبسایت سلامت ۲۰۲۶
در دنیای پرشتاب امروز، تحول دیجیتال دیگر یک گزینه نیست، بلکه ضرورتی برای بقا و پیشرفت در هر صنعتی، به ویژه حوزه حساس و حیاتی سلامت است. آزمایشگاههای تخصصی پاتوبیولوژی، به عنوان یکی از ارکان اصلی تشخیص و درمان، نقش بیبدیلی در سلامت جامعه ایفا میکنند. با این حال، بسیاری از این مراکز هنوز با چالشهایی در زمینه دسترسیپذیری، مدیریت زمان و بهینهسازی تجربه بیماران (UX) مواجه هستند. در شهر مقدس مشهد، که قطب مهمی در ارائه خدمات درمانی به شمار میرود، نیاز به توسعه وب و طراحی پرتال نوبتدهی آنلاین برای این آزمایشگاهها بیش از پیش احساس میشود. این مقاله به بررسی جامع چگونگی طراحی یک پرتال سلامت آنلاین مدرن میپردازد که نه تنها فرآیند نوبتدهی آنلاین را متحول سازد، بلکه با تمرکز بر تجربه کاربری بیماران (UX)، استانداردهای وبسایت سلامت ۲۰۲۶ را برآورده کند و راهی نوین برای تعامل بیماران با آزمایشگاه پاتوبیولوژی ترسیم نماید.
آیا به دنبال تحول دیجیتال آزمایشگاه خود هستید؟
«پینو سایت» با بهرهگیری از جدیدترین فناوریهای توسعه وب نظیر Laravel، React، Vue و Node.js، آماده است تا بهترین خدمات طراحی وبسایت و ساخت سایت تخصصی را برای آزمایشگاههای پاتوبیولوژی شما ارائه دهد.
همین حالا با پینو سایت تماس بگیرید
یا با ما تماس بگیرید: ۰۹۹۲۷۰۲۸۴۶۳
فهرست مطالب:
- ضرورت تحول دیجیتال در آزمایشگاههای پاتوبیولوژی
- توسعه وب برای آزمایشگاههای پاتوبیولوژی: زیرساخت دیجیتال مدرن
- طراحی پرتال نوبتدهی آنلاین: قلب تپنده تعامل
- ارتقاء تجربه کاربری بیماران (UX) در وبسایتهای سلامت
- وبسایت سلامت ۲۰۲۶: فراتر از یک پرتال ساده
- چالشها و ملاحظات پیادهسازی در مشهد
- سؤالات متداول
- نتیجهگیری و فراخوان به عمل
ضرورت تحول دیجیتال در آزمایشگاههای پاتوبیولوژی
عصر حاضر را میتوان دوران اطلاعات و سرعت نامید. در این میان، بخش سلامت نیز از این قاعده مستثنی نیست. بیماران امروزی به دنبال راهکارهای سریع، آسان و شفاف برای دسترسی به خدمات درمانی هستند. این نیاز، به ویژه در مراکزی مانند آزمایشگاه پاتوبیولوژی که زمان و دقت نقش حیاتی دارند، پررنگتر میشود. سیستمهای سنتی نوبتدهی و پذیرش، با صفهای طولانی، بوروکراسی اداری و محدودیتهای زمانی، نه تنها باعث نارضایتی بیماران میشوند، بلکه بار کاری مضاعفی را بر دوش پرسنل آزمایشگاه قرار میدهند.
اهمیت زمان و دقت در خدمات آزمایشگاهی
تشخیص به موقع بیماریها و ارائه نتایج دقیق آزمایشگاهی، میتواند سرنوشتساز باشد. تأخیر در نوبتگیری، رفتوآمد و انتظار در آزمایشگاهها، نه تنها به ضرر بیمار است، بلکه میتواند روند درمان را نیز تحتالشعاع قرار دهد. یک سیستم نوبتدهی آنلاین کارآمد، با کاهش زمان انتظار و بهینهسازی فرآیند پذیرش، گامی بزرگ در جهت افزایش دقت و کارایی خدمات آزمایشگاهی برمیدارد.
چالشهای سنتی نوبتدهی و پذیرش
- صفهای طولانی و اتلاف وقت: بیماران مجبور به صرف زمان طولانی در محیط آزمایشگاه هستند.
- خطاهای انسانی: ثبت دستی اطلاعات و نوبتها میتواند منجر به اشتباهات سهوی شود.
- عدم شفافیت: بیماران اطلاعات کافی در مورد زمانهای خالی و مراحل بعدی فرآیند ندارند.
- بار کاری بالای پرسنل: کارکنان آزمایشگاه زمان زیادی را صرف پاسخگویی تلفنی و مدیریت نوبتهای حضوری میکنند.
آینده سلامت ۲۰۲۶ و انتظارات بیماران
با پیشرفت تکنولوژی، انتظارات بیماران نیز دستخوش تغییر شده است. آنها به دنبال خدمات دیجیتال، شخصیسازی شده و در دسترس از هر مکان و در هر زمان هستند. وبسایت سلامت ۲۰۲۶ باید به این نیازها پاسخ دهد و با ارائه امکاناتی مانند نوبتدهی آنلاین، دسترسی به سوابق آزمایشگاهی و مشاوره آنلاین، تجربه کاربری را به طور چشمگیری ارتقاء بخشد. این رویکرد نه تنها رضایت بیماران را افزایش میدهد، بلکه جایگاه رقابتی آزمایشگاه را در بازار خدمات درمانی مشهد تقویت میکند. همانطور که در مقالهای با عنوان “CRM پزشکی و نرمافزارهای مدیریت مطب برای فوق تخصصان گوارش و کبد در تبریز: بهینهسازی نوبتدهی آنلاین و وبسایت سلامت ۲۰۲۶” نیز به آن اشاره شده، تحول دیجیتال کلید موفقیت در آینده سلامت است.
توسعه وب برای آزمایشگاههای پاتوبیولوژی: زیرساخت دیجیتال مدرن
برای ایجاد یک پرتال نوبتدهی آنلاین و وبسایت سلامت ۲۰۲۶ که پاسخگوی نیازهای پیچیده یک آزمایشگاه پاتوبیولوژی باشد، نیاز به یک زیرساخت توسعه وب قوی و مدرن است. این زیرساخت باید نه تنها امکانات فعلی را پوشش دهد، بلکه قابلیت مقیاسپذیری و انعطافپذیری برای نیازهای آینده را نیز داشته باشد. «پینو سایت» با تخصص در طراحی وبسایت در ایران و استفاده از تکنولوژیهای روز دنیا، راهحلهای مناسبی را برای این منظور ارائه میدهد.
انتخاب فناوریهای نوین (Laravel، React، Vue، Node.js)
انتخاب تکنولوژی مناسب در توسعه وب، سنگ بنای یک پروژه موفق است. فریمورکهای مدرنی مانند Laravel در سمت سرور، به دلیل قدرت، امنیت و سرعت توسعه، گزینهای ایدهآل برای مدیریت پیچیدگیهای دیتابیس و منطق تجاری یک سیستم نوبتدهی آنلاین هستند. در سمت کلاینت، فریمورکهای جاوا اسکریپت مانند React و Vue.js، امکان ساخت رابطهای کاربری پویا، واکنشگرا و با تجربه کاربری بیماران عالی را فراهم میکنند. Node.js نیز برای ساخت APIهای سریع و Real-time میتواند بسیار مفید باشد. این ترکیب تکنولوژیها، به «پینو سایت» امکان میدهد تا ساخت سایت و پرتالهای بسیار کارآمد و بهروز را برای آزمایشگاه پاتوبیولوژی در مشهد انجام دهد.
معماری مقیاسپذیر و امن
یک وبسایت سلامت باید از نظر امنیتی در بالاترین سطح قرار گیرد، زیرا با اطلاعات حساس بیماران سروکار دارد. رعایت استانداردهای امنیتی دادهها (مانند GDPR یا HIPAA در سطح بینالمللی و قوانین مربوطه در ایران) و استفاده از پروتکلهای رمزنگاری پیشرفته، از الزامات اساسی است. علاوه بر این، معماری سایت باید مقیاسپذیر باشد تا با افزایش تعداد کاربران و حجم دادهها، عملکرد آن تحت تأثیر قرار نگیرد و بتواند بدون مشکل به رشد آزمایشگاه کمک کند. طراحی وبسایت با رویکرد Microservices میتواند در این زمینه بسیار مؤثر باشد.
یکپارچگی با سیستمهای داخلی آزمایشگاه (LIS)
یکی از مهمترین جنبههای توسعه وب برای آزمایشگاهها، یکپارچگی seamless با سیستمهای مدیریت اطلاعات آزمایشگاهی (LIS) موجود است. این یکپارچگی امکان میدهد تا:
- نوبتهای رزرو شده به صورت خودکار در سیستم LIS ثبت شوند.
- نتایج آزمایشها پس از آماده شدن، به صورت امن در پرتال سلامت آنلاین در دسترس بیماران قرار گیرند.
- اطلاعات دموگرافیک بیماران بدون نیاز به ورود مجدد، بین سیستمها تبادل شوند.
این همگامسازی، خطاهای انسانی را کاهش داده، کارایی را افزایش داده و تجربه کاربری بیماران را بهبود میبخشد. همانطور که در مقاله “توسعه وب و CRM پزشکی برای آزمایشگاههای تشخیص طبی در مشهد: ارتقاء نرمافزارهای مدیریت وبسایت سلامت ۲۰۲۶” نیز تاکید شده، این یکپارچگی حیاتی است.
«پینو سایت»: همکار معتمد شما در دنیای دیجیتال پزشکی
«پینو سایت» با سابقه درخشان در توسعه وب و طراحی وبسایت برای مراکز درمانی و آزمایشگاهها، به شما کمک میکند تا با بهرهگیری از آخرین تکنولوژیها (مانند Laravel، React، Vue، Node.js) یک وبسایت سلامت ۲۰۲۶ و پرتال نوبتدهی آنلاین اختصاصی برای آزمایشگاه پاتوبیولوژی خود در مشهد داشته باشید.
یا با ما تماس بگیرید: ۰۹۹۲۷۰۲۸۴۶۳
طراحی پرتال نوبتدهی آنلاین: قلب تپنده تعامل
پرتال نوبتدهی آنلاین، نقطه تماس اصلی بیماران با آزمایشگاه پاتوبیولوژی در فضای دیجیتال است. طراحی این پرتال باید به گونهای باشد که حداکثر کارایی، سادگی و رضایتمندی را برای تجربه کاربری بیماران به ارمغان آورد. این به معنای فراتر رفتن از یک فرم ساده و ایجاد یک سیستم هوشمند است.
ویژگیهای کلیدی یک سیستم نوبتدهی آنلاین کارآمد
- انتخاب سرویس و پزشک (در صورت نیاز): امکان انتخاب نوع آزمایش، یا حتی نوبتگیری برای مشاوره با پزشک پاتولوژیست (در صورت ارائه چنین خدماتی).
- مدیریت زمان و ظرفیت: نمایش دقیق زمانهای خالی بر اساس ظرفیت آزمایشگاه و نوع آزمایش، برای جلوگیری از شلوغی و تداخل.
- یادآوری هوشمند: ارسال پیامک یا ایمیل یادآوری برای بیماران قبل از موعد نوبت، کاهش غیبت و فراموشی نوبت.
- پرداخت آنلاین: امکان پرداخت هزینه آزمایشها به صورت آنلاین، سهولت بیشتر برای بیمار و کاهش بار کاری بخش پذیرش.
- لغو و تغییر نوبت: قابلیت لغو یا تغییر نوبت به صورت آنلاین توسط بیمار، با رعایت قوانین آزمایشگاه.
- پروفایل کاربری: امکان ایجاد پروفایل شخصی برای بیماران جهت مشاهده نوبتهای قبلی، آتی و دسترسی به نتایج.
اهمیت سادگی و دسترسیپذیری
رابط کاربری (UI) باید آنقدر ساده و بصری باشد که کاربران با هر سطح دانش فنی بتوانند به راحتی از آن استفاده کنند. مراحل نوبتدهی آنلاین باید حداقل ممکن باشد و اطلاعات به صورت واضح و بدون ابهام ارائه شوند. دسترسیپذیری (Accessibility) برای افراد با تواناییهای مختلف (مانند کمبینایان) نیز باید در نظر گرفته شود. این سادگی و دسترسیپذیری، سنگ بنای یک تجربه کاربری بیماران مثبت است.
شخصیسازی تجربه کاربری برای آزمایشگاه پاتوبیولوژی
یک آزمایشگاه پاتوبیولوژی نیازهای خاص خود را دارد. ممکن است برخی آزمایشها نیاز به آمادگی قبلی داشته باشند (مثل ناشتا بودن). پرتال نوبتدهی آنلاین باید قادر به ارائه این اطلاعات به صورت واضح و در زمان مناسب باشد. همچنین، امکان فیلتر کردن آزمایشها بر اساس نوع، زمان انجام و یا تخصص مورد نیاز، میتواند تجربه کاربری بیماران را بسیار بهبود بخشد. طراحی وبسایت باید با توجه به این جزئیات دقیق انجام شود.
ارتقاء تجربه کاربری بیماران (UX) در وبسایتهای سلامت
تجربه کاربری بیماران (UX) فراتر از زیبایی ظاهری یک وبسایت سلامت است. این به معنای طراحی سیستمی است که پاسخگوی نیازها، احساسات و انتظارات کاربران باشد. در حوزه پزشکی، UX خوب میتواند تفاوت بین رضایت و نارضایتی، و حتی بین انتخاب یک آزمایشگاه نسبت به دیگری باشد. برای آزمایشگاه پاتوبیولوژی در مشهد، تمرکز بر UX در توسعه وب از اهمیت ویژهای برخوردار است.
اصول طراحی UX در حوزه پزشکی
- ناوبری بصری و ساده: کاربران باید بتوانند بدون سردرگمی، به سرعت به اطلاعات و بخشهای مورد نظر خود دسترسی پیدا کنند. منوها باید واضح و منطقی باشند.
- طراحی ریسپانسیو و موبایلفرندلی: بخش عمدهای از کاربران از طریق تلفن همراه به پرتال سلامت آنلاین مراجعه میکنند. وبسایت سلامت باید در تمامی دستگاهها (کامپیوتر، تبلت، موبایل) تجربه کاربری یکسانی ارائه دهد.
- اطلاعات شفاف و قابل اعتماد: ارائه اطلاعات دقیق در مورد آزمایشها، آمادگیهای لازم، هزینهها و مراحل بعدی به صورت واضح، باعث افزایش اعتماد بیمار میشود.
- بازخورد و پشتیبانی: وجود راههای ارتباطی آسان برای طرح سؤالات و ارائه بازخورد، نشاندهنده احترام به بیمار است و تجربه کاربری بیماران را بهبود میبخشد.
- حفظ حریم خصوصی: با توجه به حساسیت اطلاعات پزشکی، کاربران باید از امنیت و حفظ حریم خصوصی دادههای خود اطمینان داشته باشند. این مورد باید در طراحی وبسایت در نظر گرفته شود.
مطالعه موردی: نیازهای خاص بیماران آزمایشگاه پاتوبیولوژی
بیمارانی که به آزمایشگاه پاتوبیولوژی مراجعه میکنند، ممکن است در شرایط استرس یا نگرانی باشند. بنابراین، پرتال سلامت آنلاین باید محیطی آرامبخش، اطمینانبخش و کارآمد را فراهم کند. این شامل موارد زیر میشود:
- ارائه توضیحات ساده و قابل فهم در مورد هر آزمایش.
- امکان دسترسی به نتایج آزمایشها به صورت امن و سریع.
- پشتیبانی آنلاین یا تلفنی برای پاسخگویی به سؤالات فوری.
- اطلاعرسانی در مورد وضعیت نوبت و آمادگیهای لازم.
مقاله “طراحی سایت پزشکی و UX بیماران برای کلینیکهای جراحی دهان، فک و صورت در اصفهان: بهینهسازی نوبتدهی آنلاین ۲۰۲۶” نیز بر اهمیت این جزئیات در طراحی وبسایت پزشکی تاکید دارد.
نقش طراحی UI در ایجاد اعتماد و رضایت
طراحی رابط کاربری (UI) نه تنها باید زیبا باشد، بلکه باید عملکردی و مؤثر نیز باشد. رنگها، فونتها، آیکونها و چیدمان عناصر همگی باید به گونهای انتخاب شوند که احساس حرفهای بودن، اعتماد و آرامش را به کاربر منتقل کنند. UI باید حس سادگی و کارآمدی را به کاربر القا کند تا او به راحتی بتواند از خدمات نوبتدهی آنلاین و سایر امکانات وبسایت سلامت استفاده کند. یک طراحی وبسایت جذاب و کاربرپسند، میتواند بیماران بیشتری را به سمت آزمایشگاه پاتوبیولوژی در مشهد جذب کند.
وبسایت سلامت ۲۰۲۶: فراتر از یک پرتال ساده
وبسایت سلامت ۲۰۲۶ چیزی فراتر از یک سیستم نوبتدهی آنلاین ساده است. این یک اکوسیستم جامع دیجیتال است که تمامی نیازهای بیمار و آزمایشگاه را در یک بستر یکپارچه پاسخ میدهد. با توسعه وب هوشمند، میتوان امکانات پیشرفتهای را به پرتال سلامت آنلاین اضافه کرد که تجربه مراقبتهای بهداشتی را به کلی متحول میسازد.
امکانات هوشمند: هوش مصنوعی و یادگیری ماشین
ادغام هوش مصنوعی (AI) و یادگیری ماشین (ML) میتواند سطح جدیدی از خدمات را به وبسایت سلامت اضافه کند:
- پاسخگویی خودکار (Chatbot): یک چتبات هوشمند میتواند به سؤالات متداول بیماران در مورد آزمایشها، آمادگیها، ساعات کاری و حتی وضعیت نوبتها به صورت ۲۴/۷ پاسخ دهد.
- توصیههای شخصیسازی شده: بر اساس سوابق پزشکی و آزمایشگاهی بیمار، سیستم میتواند توصیههای بهداشتی یا یادآوری برای آزمایشهای دورهای ارائه دهد.
- تحلیل دادهها: استفاده از ML برای تحلیل الگوهای نوبتدهی آنلاین، زمانهای اوج مراجعات و بهینهسازی ظرفیت آزمایشگاه.
این امکانات هوشمند، تجربه کاربری بیماران را بسیار غنیتر میکنند و کارایی آزمایشگاه پاتوبیولوژی را در مشهد افزایش میدهند.
داشبوردهای شخصیسازی شده برای بیماران و کادر درمانی
ایجاد داشبوردهای اختصاصی برای هر گروه از کاربران، امکان مدیریت بهتر و دسترسی آسانتر به اطلاعات را فراهم میکند.
- داشبورد بیماران: شامل سوابق آزمایشگاهی، نوبتهای آتی، امکان دانلود نتایج، اطلاعات تماس با آزمایشگاه و آموزشهای بهداشتی مرتبط.
- داشبورد کادر درمانی/پزشکان: امکان مشاهده نوبتهای رزرو شده، نتایج آزمایشها، گزارشهای مدیریتی، و ابزارهای ارتباطی داخلی.
این داشبوردها باعث شفافیت و کارایی بیشتر در مدیریت آزمایشگاه پاتوبیولوژی میشوند و ارزش افزوده زیادی برای پرتال سلامت آنلاین خواهند داشت.
محتوای آموزشی و اطلاعرسانی سلامت
یک وبسایت سلامت ۲۰۲۶ باید منبعی قابل اعتماد برای اطلاعات سلامت باشد. بخش وبلاگ یا مقالات آموزشی، با محتوای مرتبط با آزمایشهای پاتوبیولوژی، پیشگیری از بیماریها و سبک زندگی سالم، میتواند به افزایش آگاهی بیماران کمک کند. این کار نه تنها به بیماران ارزش میدهد، بلکه به بهبود سئو (SEO) سایت و جذب ترافیک ارگانیک نیز کمک میکند. طراحی وبسایت با بخش محتوای قوی، آزمایشگاه را به یک مرجع معتبر تبدیل میکند.
یکپارچگی با سایر خدمات سلامت دیجیتال (پرتال سلامت آنلاین)
آینده سلامت در یکپارچگی است. پرتال سلامت آنلاین آزمایشگاه باید قابلیت ادغام با سایر سامانههای سلامت مانند پرونده الکترونیک سلامت، سیستمهای ارجاع پزشکان و حتی برنامههای پایش سلامت شخصی را داشته باشد. این یکپارچگی، تجربه کاربری بیماران را به یک سطح جامعتر ارتقا میدهد و دسترسی به خدمات را سادهتر میکند. این رویکرد پیشرفته توسعه وب، آزمایشگاه را برای سال ۲۰۲۶ و فراتر از آن آماده میسازد.
چالشها و ملاحظات پیادهسازی در مشهد
پیادهسازی یک پرتال نوبتدهی آنلاین و وبسایت سلامت ۲۰۲۶ در مشهد، علاوه بر مزایای بیشمار، چالشها و ملاحظات خاص خود را دارد که باید در فرآیند توسعه وب و طراحی وبسایت به آنها توجه شود.
الزامات قانونی و امنیتی دادهها
حفظ حریم خصوصی و امنیت اطلاعات بیماران، مهمترین ملاحظه در پرتال سلامت آنلاین است. تمامی دادههای پزشکی و شخصی باید مطابق با قوانین و مقررات جمهوری اسلامی ایران ذخیره و پردازش شوند. استفاده از پروتکلهای امنیتی SSL، رمزنگاری دیتابیس، و رعایت استانداردهای امنیتی سایبری، ضروری است. تیم پینو سایت با آگاهی کامل از این الزامات، ساخت سایت را با بالاترین استانداردهای امنیتی انجام میدهد.
جذب و آموزش پرسنل
معرفی یک سیستم جدید نوبتدهی آنلاین، نیازمند آموزش کافی پرسنل آزمایشگاه است. آنها باید با نحوه کارکرد پرتال، مدیریت نوبتها، پاسخگویی به سؤالات بیماران و استفاده از داشبوردهای مدیریتی آشنا شوند. سرمایهگذاری در آموزش، تضمین میکند که سیستم جدید به درستی و به طور کامل مورد استفاده قرار گیرد و مقاومت در برابر تغییر به حداقل برسد.
رقابت در بازار خدمات دیجیتال پزشکی مشهد
مشهد به عنوان یکی از شهرهای بزرگ و مهم ایران، بازار رقابتی در حوزه خدمات پزشکی دارد. آزمایشگاه پاتوبیولوژی برای متمایز شدن، نیاز به طراحی وبسایت و پرتال نوبتدهی آنلاینی دارد که نه تنها کارآمد باشد، بلکه از نظر ظاهری و تجربه کاربری بیماران نیز در سطح بالایی قرار گیرد. این تمایز میتواند با ارائه خدمات منحصر به فرد یا امکانات پیشرفته محقق شود. مقالاتی مانند “طراحی سایت پزشکی پیشرفته برای فوق تخصص قلب و عروق در مشهد: بهینهسازی UX بیماران و نوبتدهی آنلاین ۲۰۲۶” نیز این رقابت را در مشهد نشان میدهند.
مزیت رقابتی با طراحی وبسایت در ایران توسط متخصصین بومی
همکاری با شرکتهای توسعه وب بومی مانند «پینو سایت»، که درک عمیقی از فرهنگ، نیازهای بازار و زیرساختهای فناوری در ایران دارند، میتواند مزیت رقابتی بزرگی باشد. این شرکتها میتوانند راهکارهایی را ارائه دهند که به طور خاص برای محیط ایران بهینه شدهاند و پشتیبانی محلی قویتری را فراهم کنند. همچنین قیمت طراحی وبسایت در ایران معمولاً اقتصادیتر است در حالی که کیفیت جهانی ارائه میشود. تخصص «پینو سایت» در طراحی وبسایت در ایران و استفاده از فریمورکهای قدرتمندی مانند Laravel، Vue، React و Node.js، تضمینکننده کیفیت و کارایی است.
«پینو سایت»: پیشرو در طراحی وبسایتهای پزشکی و آزمایشگاهی
«پینو سایت» با تیمی متخصص و با تجربه در توسعه وب و طراحی وبسایت، راهحلهای نوآورانه و سفارشی را برای آزمایشگاه پاتوبیولوژی شما در مشهد ارائه میدهد. از نوبتدهی آنلاین گرفته تا پرتال سلامت آنلاین با تمرکز بر تجربه کاربری بیماران، ما مسیر دیجیتالی شما را هموار میکنیم. با Laravel، React، Vue و Node.js، ما بهترینها را برای شما میسازیم.
همین حالا پروژهتان را آغاز کنید
یا با ما تماس بگیرید: ۰۹۹۲۷۰۲۸۴۶۳
سؤالات متداول درباره توسعه وب و طراحی پرتال نوبتدهی آنلاین برای آزمایشگاهها
در این بخش، به برخی از سؤالات متداولی که ممکن است در مورد توسعه وب و طراحی پرتال نوبتدهی آنلاین برای آزمایشگاه پاتوبیولوژی داشته باشید، پاسخ میدهیم:
چرا آزمایشگاه پاتوبیولوژی من به یک پرتال نوبتدهی آنلاین نیاز دارد؟
یک پرتال نوبتدهی آنلاین، فرآیند دسترسی بیماران به خدمات آزمایشگاه را سادهتر، سریعتر و شفافتر میکند. این امر باعث افزایش رضایت بیماران، کاهش بار کاری پرسنل و افزایش کارایی کلی آزمایشگاه پاتوبیولوژی میشود. همچنین، شما را با استانداردهای وبسایت سلامت ۲۰۲۶ همسو میسازد و به حفظ رقابت در مشهد کمک میکند.
توسعه وب سفارشی برای آزمایشگاه چه مزایایی دارد؟
توسعه وب سفارشی، این امکان را میدهد که پرتال دقیقاً بر اساس نیازهای منحصر به فرد آزمایشگاه پاتوبیولوژی شما طراحی شود و با سیستمهای داخلی (مانند LIS) یکپارچه گردد. این رویکرد، انعطافپذیری و مقیاسپذیری بیشتری نسبت به راهکارهای آماده ارائه میدهد و تجربه کاربری بیماران را بهینهسازی میکند.
امنیت اطلاعات بیماران در پرتال نوبتدهی آنلاین چگونه تضمین میشود؟
«پینو سایت» در ساخت سایت و پرتال سلامت آنلاین، از پیشرفتهترین پروتکلهای امنیتی و رمزنگاری دادهها استفاده میکند. رعایت کامل استانداردهای حریم خصوصی و امنیت اطلاعات پزشکی، و پیادهسازی گواهینامههای SSL و فایروالهای قدرتمند، از اولویتهای اصلی ما برای محافظت از اطلاعات بیماران است.
چه فناوریهایی برای توسعه یک وبسایت سلامت مدرن استفاده میشود؟
برای توسعه وب مدرن و قدرتمند، از ترکیبی از فناوریهای پیشرفته مانند Laravel (برای بکاند)، React یا Vue.js (برای فرانتاند) و Node.js (برای توسعه APIها و عملکردهای Real-time) استفاده میشود. این فناوریها امکان طراحی وبسایتهای سریع، ایمن و کاربرپسند را فراهم میکنند.
چگونه میتوان تجربه کاربری بیماران (UX) را در پرتال بهبود بخشید؟
برای ارتقاء تجربه کاربری بیماران، باید بر طراحی بصری و ساده، ناوبری آسان، طراحی ریسپانسیو، ارائه اطلاعات شفاف و قابل اعتماد، و امکان ارتباط و بازخورد تمرکز کرد. هرچه فرآیند نوبتدهی آنلاین سادهتر و اطلاعات قابل دسترستر باشد، UX بهبود مییابد.
آیا پرتال نوبتدهی آنلاین میتواند به سئو سایت آزمایشگاه کمک کند؟
بله، طراحی وبسایت با پرتال نوبتدهی آنلاین که به درستی بهینهسازی شده باشد، میتواند به سئو سایت کمک کند. با ارائه محتوای با کیفیت، سرعت بارگذاری بالا، طراحی ریسپانسیو و لینکهای داخلی مناسب، موتورهای جستجو سایت شما را بیشتر مورد توجه قرار میدهند و در نهایت باعث افزایش دید و جذب مراجعین بیشتر به آزمایشگاه پاتوبیولوژی در مشهد میشود.
هزینه طراحی وبسایت و پرتال نوبتدهی آنلاین چقدر است؟
قیمت طراحی وبسایت و پرتال نوبتدهی آنلاین به عوامل مختلفی مانند پیچیدگی امکانات، طراحی سفارشی، یکپارچگی با سیستمهای دیگر و پشتیبانی بستگی دارد. «پینو سایت» پس از مشاوره رایگان و بررسی نیازهای شما، یک پیشنهاد قیمت شفاف و رقابتی ارائه خواهد داد. با ما تماس بگیرید تا در مورد قیمت طراحی وبسایت سفارشی خود صحبت کنیم.
برای کسب اطلاعات بیشتر و دریافت مشاوره، با شماره ۰۹۹۲۷۰۲۸۴۶۳ تماس بگیرید.
فرصت را از دست ندهید!
«پینو سایت» همراه شما در توسعه وب و ساخت سایتی است که نه تنها نیازهای امروز شما را برآورده میکند، بلکه آزمایشگاه شما را برای آینده سلامت دیجیتال آماده میسازد. با جدیدترین تکنولوژیها و تیم متخصص ما، بهترین پرتال سلامت آنلاین را برای آزمایشگاه پاتوبیولوژی خود در مشهد داشته باشید.
یا با ما تماس بگیرید: ۰۹۹۲۷۰۲۸۴۶۳
نتیجهگیری و فراخوان به عمل
در نهایت، توسعه وب و طراحی پرتال نوبتدهی آنلاین برای آزمایشگاههای تخصصی پاتوبیولوژی در مشهد، نه تنها یک گام رو به جلو در جهت مدرنسازی خدمات سلامت است، بلکه ضرورتی برای پاسخگویی به انتظارات فزاینده بیماران و رقابت در بازار دیجیتال محسوب میشود. با تمرکز بر تجربه کاربری بیماران (UX)، استفاده از فناوریهای نوین و ایجاد یک وبسایت سلامت ۲۰۲۶ جامع، میتوان فرآیند دسترسی به خدمات آزمایشگاهی را متحول ساخت. یک پرتال سلامت آنلاین هوشمند، نه تنها مشکلات سنتی نوبتدهی آنلاین را حل میکند، بلکه با امکانات پیشرفته خود، سطح کیفیت و رضایتمندی را به میزان قابل توجهی ارتقا میبخشد.
«پینو سایت» با بهرهگیری از دانش روز و تخصص در طراحی وبسایت در ایران، آماده است تا با استفاده از پلتفرمهای قدرتمندی نظیر Laravel، React، Vue و Node.js، رویای دیجیتالی شدن آزمایشگاه پاتوبیولوژی شما را به واقعیت تبدیل کند. ما به شما کمک میکنیم تا با ساخت سایتی امن، کارآمد و کاربرپسند، نه تنها بیماران بیشتری را جذب کنید، بلکه خدماتی در سطح استانداردهای جهانی ارائه دهید و جایگاه خود را به عنوان یک مرکز پیشرو در مشهد تثبیت نمایید.
آینده سلامت در دستان دیجیتال است. با «پینو سایت» همراه شوید و آزمایشگاه خود را برای این آینده روشن آماده کنید.
همین امروز با «پینو سایت» تماس بگیرید و آینده دیجیتال آزمایشگاه خود را رقم بزنید!
© PinoSite @ 2025 — Designed & Developed by PinoSite